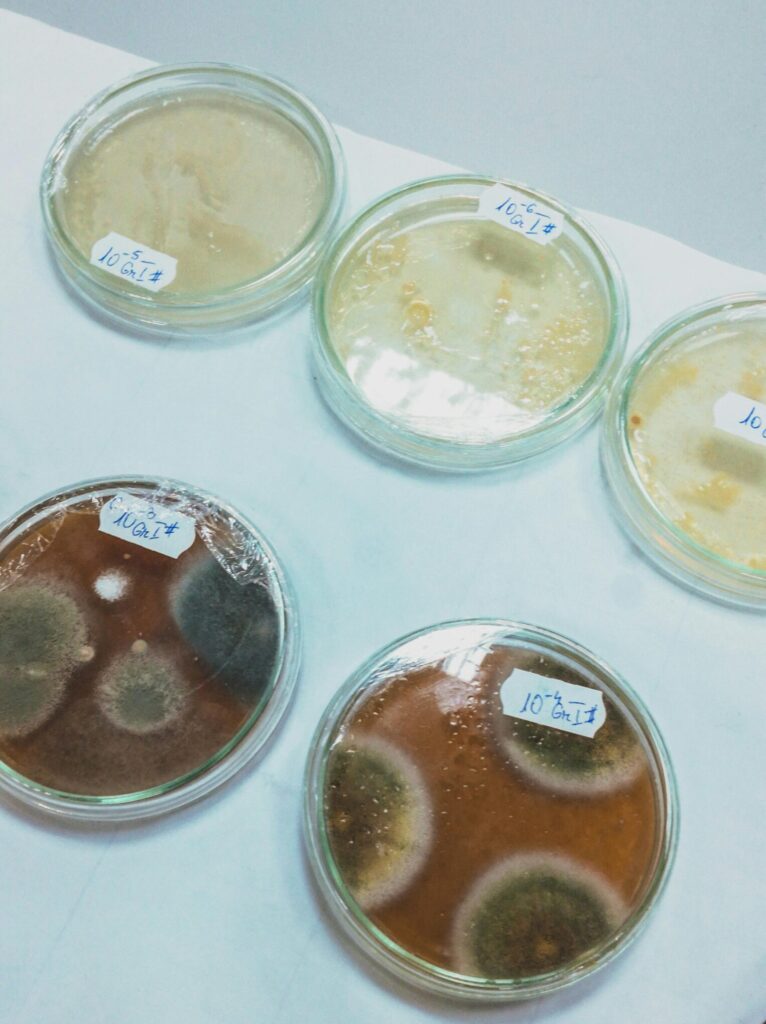

Alternaria in der Wohnung: Warum dieser schwarze Schimmel oft unterschätzt wird

Wenn Menschen in ihrer Wohnung dunkle Flecken entdecken, fällt schnell der Begriff „schwarzer Schimmel“. Das klingt eindeutig, ist es aber nicht. „Schwarzer Schimmel“ ist kein exakter Fachbegriff, sondern eine umgangssprachliche Sammelbezeichnung für verschiedene dunkel erscheinende Schimmelarten. Eine davon ist Alternaria und gerade diese Gattung ist aus medizinischer Sicht besonders interessant, weil sie weltweit zu den […]
Wenn die Wohnung krank macht: Ab wann ist Schimmel gefährlich – auch ohne sichtbaren Befall?

Foto: Alexander Grey via Unsplash Viele Menschen glauben, Schimmel sei erst dann ein Problem, wenn große schwarze Flecken an der Wand sichtbar sind. Aus bauphysikalischer und medizinischer Sicht ist diese Annahme jedoch zu einfach. Schimmel kann die Gesundheit beeinflussen, lange bevor er sichtbar wird. Besonders problematisch ist, dass Symptome oft unspezifisch sind und deshalb nicht sofort mit der […]
Kann Schimmel müde machen? Warum viele Betroffene über Erschöpfung und Brain Fog berichten

Viele Menschen berichten, dass sie sich in ihrer Wohnung dauerhaft müde fühlen. Sie schlafen ausreichend, ernähren sich normal – und sind trotzdem erschöpft. Häufig kommen zusätzlich Konzentrationsprobleme, Kopfschmerzen oder ein Gefühl von „Nebel im Kopf“ (Brain Fog) dazu. Nicht selten stellt sich später heraus: In der Wohnung besteht ein Feuchtigkeitsproblem oder Schimmelbefall. Doch kann Schimmel […]
Schimmelanalyse: Klebestreifen oder Luftprobe? Welche Methode wirklich sinnvoll ist
Foto von Czapp Árpád Wann ist eine Schimmelanalyse notwendig? Ursachen erkennen statt Symptome übersehen Viele Menschen fragen sich: Wann braucht es überhaupt eine Schimmelanalyse?Ist sie nur bei sichtbaren Flecken notwendig oder auch dann, wenn lediglich ein muffiger Geruch wahrnehmbar ist? Die kurze Antwort:Eine Schimmelanalyse ist immer dann sinnvoll, wenn der Verdacht besteht, dass Feuchtigkeit oder […]
Schimmel macht krank – was Ärzte über Mykotoxine und chronische Beschwerden wirklich sagen

Foto: freepeek Schimmel in Innenräumen wird häufig als rein bauliches Problem betrachtet. Feuchte Wände, dunkle Flecken oder ein modriger Geruch gelten vielen Menschen vor allem als kosmetisches oder hygienisches Problem. In den letzten Jahrzehnten hat sich jedoch ein wachsendes Forschungsfeld entwickelt, das sich mit der Frage beschäftigt, wie sich Schimmel und die von ihm produzierten […]
Schimmel in Gebäuden – was sagt die Wissenschaft und was berichten Experten aus der Praxis?

Foto: unathi-tshabalala via unsplash Schimmel in der Wohnung – wissenschaftliche Erkenntnisse und praktische Erfahrungen von Experten Schimmel in Wohnungen ist ein Thema, das viele Menschen beschäftigt. Sobald dunkle Flecken an einer Wand erscheinen oder ein muffiger Geruch wahrgenommen wird, stellt sich schnell die Frage, wie gefährlich das Problem tatsächlich ist und woher es kommt. In […]
Mykotoxine – unsichtbare Stoffwechselprodukte von Schimmelpilzen

Foto: Dmytro Vynohradov via Unsplash Wenn über Schimmel in Wohnungen gesprochen wird, denken die meisten Menschen zuerst an sichtbare Flecken an Wänden oder an den typischen muffigen Geruch. Weniger bekannt ist, dass einige Schimmelpilze auch chemische Stoffe produzieren können, die als Mykotoxine bezeichnet werden. Der Begriff setzt sich aus zwei Teilen zusammen:„Myko“ bedeutet Pilz und „Toxin“ bedeutet […]
Schimmel in der Wohnung und mögliche Auswirkungen auf die Gesundheit – wie der Körper unterstützt werden kann

Foto: pexels-cottonbro Eininge Menschen suchen neben der Beseitigung der Schimmelquelle nach Möglichkeiten, ihren Körper zu unterstützen. Bestimmte Nährstoffe und natürliche Substanzen werden dabei als unterstützende Maßnahmen diskutiert. Schimmel in Wohnräumen ist nicht nur ein bauliches Problem. Viele Menschen berichten auch über gesundheitliche Beschwerden, wenn sie über längere Zeit Schimmelsporen ausgesetzt sind. Besonders in schlecht belüfteten […]
